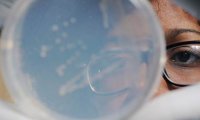
Вокруг каждого человека находится уникальное облако бактерий

В Румынии сократили размер арестованных счетов ЛУКОЙЛа
Суд румынского уезда Прахова после смены прокурора, пересчитавшего размер ущерба, якобы причиненного ЛУКОЙЛом, снизил размер арестованных счетов компании.

Суд румынского уезда Прахова после смены прокурора, пересчитавшего размер ущерба, якобы причиненного ЛУКОЙЛом, снизил размер арестованных счетов компании.

Украина, как заявляла и ранее, намерена реструктуризировать свои долги, в частности и перед Россией, хотя последняя не видит оснований для включения долга ей в список реструктуризации.

Создана компьютерная система, которая распознает рукописный китайский текст эффективнее человека. Есть и другие достижения искусственного интеллекта, которые могут облегчить нашу жизнь.

Нашими решениями очень легко манипулировать: магнитная стимуляция определенной области мозга изменяет представления человека о справедливости, выяснили ученые.

Результаты нового исследования американских ученых шокировали общественность. Оказалось, что 96% профессиональных игроков в американский футбол страдают энцефалопатией, но даже и не догадываются об...

Лоукостер «Аэрофлота» – авиакомпания «Победа» – запустила распродажу билетов, хотя ранее реклама перевозчика о низких ценах на перелеты вызывала негодование ФАС.

Ученые нашли объяснение захватывающим ледяным пейзажам, открывшимся перед ними на снимках с Плутона. Геологи увидели на карликовой планете то, что давно наблюдают в Арктике и Антарктике.
Американские ученые попытались выяснить состав бактерий, которые люди выбрасывают в воздух при дыхании. О новом измерении микробиома человека сообщается в журнале PeerJ.

Депутат Евгений Федоров, который является членом комитета Госдумы по бюджету и налогам, разработал законопроект, регламентирующий своего рода эмбарго на использование валюты для компаний и банков.

Правительство ответило дефициту «нет». А президент Владимир Путин оказал поддержку Министерству финансов в поисках денег. Он объявил, что запланированный дефицит бюджета на будущий год не должен быть...

Международный коллектив ученых создал и опробовал в эксперименте методику для оценки умственных способностей птиц. Исследование было опубликовано в Animal Behaviour.

Ученые из Университета Ноттингема сообщили о том, что для суставов пиво вреднее, чем вино. Из-за употребления пива люди рискуют столкнуться с остеоартритом коленного сустава.

Современные дети все чаще отказываются от полезных продуктов в пользу фаст-фуда и газировки. Однако ученые не теряют надежду приучить новое поколение к овощам и фруктам.

На строящейся в Сирии российской авиабазе планируется разместить около 2 тыс. человек. Источники Financial Times утверждают, что это вполне соизмеримо с численностью контингента на авиабазах в...

Крупнейший европейский модный бренд одежды H&M представил свою новую коллекцию одежды, в которой одной из центральных фигур оказалась модель в хиджабе.

Известная французская певица Патрисия Каас готовит новый диск, который будет десятым полноформатным альбомом в музыкальной карьере поп-джаз-исполнительницы.

Российское государство займется перестрахованием. Правительство совместно с Центральным банком согласовали вопрос существования государственного перестраховщика.

Многие ученые сходятся во мнении, что Луну в скором будущем удастся превратить в планету для жизни. Уже сейчас достаточно обеспеченные жители Земли имеют собственные участки на нашем спутнике.

Жерому Вальке сообщили о его отставке по дороге в Москву после церемонии запуска часов обратного отсчета до начала всемирного чемпионата по футболу 2018 года.

В Германии следствие предъявило 91-летней женщине обвинения в причастности к 260 тыс. убийств в Освенциме. Представитель следственных органов Шлезвиг-Гольштейна Хайнц Дойлель заявил, что обвиняемая...